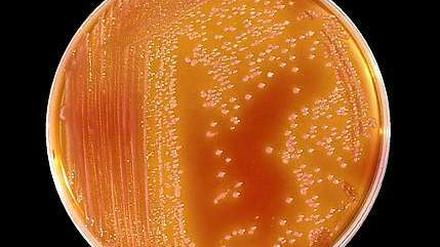

Am siebten Spieltag kassierte Eintracht Frankfurt die erste Saisonniederlage. Doch der Aufsteiger ist in die Erfolgsspur zurückgekehrt. Nach dem Sieg gegen Hannover vermerkt Dominik Bardow: Die Eintracht hat ihre Lektion gelernt.

Am siebten Spieltag kassierte Eintracht Frankfurt die erste Saisonniederlage. Doch der Aufsteiger ist in die Erfolgsspur zurückgekehrt. Nach dem Sieg gegen Hannover vermerkt Dominik Bardow: Die Eintracht hat ihre Lektion gelernt.

Annette Schavan hat Freud nicht gelesen und in ihrer Doktorarbeit dennoch über sein Werk geschrieben. Trotzdem kann von Täuschung oder Fälschung keine Rede sein. Höchstens von der Faulheit der Promovierenden.
Einen perfekten Schutz gegen Keimbefall gibt es nicht. Doch an der Charité ist ein Baby gestorben, ein zweites schwebt nun in Lebensgefahr. Es stellen sich Fragen, die die Klinik und die zuständigen Politiker beantworten müssen.

Die Verbreitung von Keimen in der Frühchenstation der Charité bleibt rätselhaft. Ein Baby ist gestorben, ein weiteres schwebt nun in Lebensgefahr. Experten äußern massive Kritik an den verantwortlichen Ärzten. Doch der Senat will sich nicht einmischen.

Keimbefall in der Klinik: Ein Baby ist bereits gestorben, ein zweites schwebt in Lebensgefahr. An der Charité wurde geschlampt - zu diesem Urteil kommt Klaus-Dieter Zastrow, Sprecher der Deutschen Gesellschaft für Krankenhaushygiene.
Nach dem Tod eines Säuglings wird über Hygienestandards an Krankenhäusern diskutiert. Wie konnte es zu den Infektionen kommen?
Ein Autofahrer hat am Sonntag in Haselhorst eine Fußgängerin übersehen - nun liegt die 80-Jährige schwer verletzt im Krankenhaus.

Mit einem interaktiven Comedy-Format geht der erste eigene deutsche Themen-Kanal beim Videoportal YouTube heute an den Start. In der Ankündigung wird bereits das traditionelle Fernsehen beerdigt, die privaten Rundfunkanstalten wappnen sich indes für den neuen Wettbewerber.

Wenn der Vater mit der Tochter tanzen und die Mutter mit dem Sohn Baseball spielen geht, dann ist das Geschlechterdiskriminierung. So lautet ein Gerichtsurteil, das derzeit in den USA hohe Wellen schlägt. Malte Lehming über das Ende einer Tradition und "political correctness" in Reinform.

Nach der tödlichen Schießerei im US-Staat Winsconsin, bei der mindestens drei Menschen starben, hat sich der mutmaßliche Täter offenbar selbst das Leben genommen. Die Polizei fand Hinweise auf sein Motiv.

Der Arzt Michele Ferrari half nicht nur Lance Armstrong beim Betrug. Neue Recherchen zeigen sein millionenschweres Netzwerk mit vielen Fahrern. Sein Geschäftsvolumen scheint die 30-Millionen-Grenze übertroffen zu haben.
Er soll die Macht der CSU im Freistaat brechen: Münchens Oberbürgermeister Christian Ude ist von der SPD nun auch offiziell zum Herausforderer von Horst Seehofer gewählt worden - und das mit einem beachtlichen Ergebnis.
Der Sieg von Fritz Kuhn in Stuttgart wird Folgen haben, in der Stadt, im Spitzenland Baden-Württemberg und darüber hinaus: als grünes Fanal für die kommenden Wahlen.

Der Libanon kommt nicht zur Ruhe. In der Nacht zu Montag wurde wieder geschossen. Bundesaußenminister Guido Westerwelle zeigte sich besorgt angesichts der Ereignisse und warnte vor einem "Flächenbrand" in der Region.

Was ist denn da passiert? Ein kluger Werbekopf, ein brillanter Stratege und der Macher vieler großer Marken scheitert gegen Fritz Kuhn. Stuttgarts OB ist grün, und Turner ärgert sich schwarz.
Am Montagmorgen ist es bei der Berliner S-Bahn zu Behinderungen auf mehreren Linien gekommen. Auf dem Ring begründet das Unternehmen die Verspätungen mit einem "erhöhten Fahrgastaufkommen".
Ein Jugendlicher hat am Sonntag einen Stein auf einen Polizeiwagen in Gesundbrunnen geworfen und flüchtete. Doch weit kam der 15-Jährige nicht.
Als erster Grüner darf Fritz Kuhn künftig eine deutsche Landeshauptstadt regieren. Der umstrittene Bahnhofsneubau in Stuttgart ist nun sein Problem. Bei der CDU herrschen derweil Wut und Enttäuschung.

Für richtig gute Bilder braucht es heutzutage keine Spiegelreflex-Kamera mehr. Diese Erkenntnis ist zwar nicht neu, aber mit jeder Generation neuer digitaler Kompaktkameras verfestigt sich diese These. Eine Marktübersicht.

Günther Jauch spricht mit seinen Gästen über den "gläsernen Politiker". Sein Auftritt erinnert an den der deutschen Nationalmannschaft gegen Schweden: Der Mann ist sich zu sicher, er weiß um seine Talente, er ahnt, dass er es könnte. Es wird bloß Zeit, dass er es auch mal zeigt.

Nach teils heftigen Angriffen aus der CSU will der griechische Ministerpräsident Antonis Samaras offenbar nach Bayern reisen und um Verständnis für die Griechen werben.

Spaniens Ministerpräsident kann aufatmen. Die Wähler in seiner Heimatregion Galicien unterstützen die Sparpolitik. Im Baskenland setzen sich separatistische Gruppen durch. Die großen Verlierer sind wieder die Sozialisten.
Ein mutmaßlicher Autoknacker ist in Wilmersdorf auf frischer Tat ertappt worden. Der 33-Jährige wollte ein Navigationsgerät klauen - wurde dabei aber beobachtet.
Selbst Sprecher der SPD fordern, der Bildungsministerin Annette Schavan stehe zunächst einmal ein korrektes Verfahren bei der Überprüfung ihrer Dissertation zu. Doch der SPD-Fraktionsgeschäftsführer Thomas Oppermann weiß schon jetzt, dass die Ministerin unheilbar beschädigt ist und dass sie am besten zurückzutreten hätte.
Kleinmachnow - Ein Feuer ist am Samstagabend im Kleinmachnower Seniorenheim Augustinum ausgebrochen. Zwei Personen wurden dabei leicht verletzt.
Teltow - Der Teltower Grünen-Ortsverband hat keine Rathaus-Fraktion mehr. Im nicht öffentlichen Teil der jüngsten Stadtverordneten-Versammlung wurde die Fraktion Linke/Grüne in Linke/Umweltaktive umbenannt.
Patrick Schmidt vergab vom Elfmeterpunkt
Babelsbergs Zweite spielte 0:0 unentschieden
Münster hat einen Rückschlag im Kampf um die Aufstiegsplätze hinnehmen müssen. Der Tabellenführer kam im Heimspiel gegen Offenbach nicht über ein 2:2 hinaus, bleibt aber an der Spitze.
Im Duell zweier Aufsteiger unterlag die SG Michendorf bei Dynamo Eisenhüttenstadt mit 0:2 (0:1). Den Gegner im Abstiegskampf auf Distanz halten, hatte Trainer André Kather im Vorfeld angekündigt.

Schorlemmer sprach sich in Marquardt erneut gegen Garnisonkirche aus

Die Region nimmt an bundesweitem Bioenergieregion-Projekt teil und erwägt Bau einer Anlage
Sie habe sich immer geschworen, wenn sie einmal Rentnerin sei, dann wolle sie sich noch irgendwo sinnvoll engagieren, erzählte Elke Bobertz von der Shopleitung des Potsdamer Oxfam-Geschäfts am vergangenen Samstag. Seit zehn Jahren gibt es den Laden in der Friedrich- Ebert-Straße.
FSV Babelsberg 74 ist wieder Tabellenführer

Der Musikerzirkus von Gabby Young & Other Animals begeisterte im Nikolaisaal

Poetenpack zeigte „Die Judenbank“ im T-Werk
Im Spitzenspiel der Landesliga Nord trennten sich der RSV Eintracht Teltow und Forst Borgsdorf 1:1 (0:1) unentschieden. Mit Anpfiff erarbeitete sich der RSV eine Vielzahl von Chancen, die aber alle ungenutzt blieben.
Brandenburgs Finanzminister Helmuth Markov spricht im PNN-Interview über die geplante Klage Bayerns gegen den Länderfinanzausgleich und über die Abhängigkeit Brandenburgs vom Finanztransfer.
Kai Desinger, Chef der Garage du Pont, lud am Sonntag zu einer Promi-Oldtimer-Rallye und sammelte so 3 100 Euro für Familien in Not.
In der 2. Frauen-Bundesliga beendete Turbine II die Niederlagenserie und kam am Sonntag in einer spannenden Partie zum verdienten 4:2 (2:1)-Erfolg über den favorisierten Herforder SV.
Die Verbreitung von Keimen in der Frühchenstation der Universitätsklinik in Berlin bleibt rätselhaft. Und der Senat will sich nicht einmischen

Stadtschlossverein dankt dem Spender Erik von Grawert-May / Verwendung völlig unklar
Zum Schluss ging es dann doch noch einigermaßen demokratisch zu. Mit großer Mehrheit wählten die französischen Sozialisten Harlem Désir zu ihrem neuen Parteichef.

Es war ihr Leib und Magenblatt, doch nun ging selbst das Rechtsaußenblatt „Junge Freiheit“ (JF) auf Abstand zu Saskia Ludwig.
Nach zuletzt mäßigen Leistungen konnte der Teltower FV beim Aufsteiger FC Viktoria Jüterbog mit einer überzeugenden Vorstellung einen verdienten 4:0 (1:0)-Erfolg einfahren. Vor allen im spielerischen Bereich überzeugte der TFV.

Aufsichtsrat genehmigte Pläne für 2013 / Photovoltaik in Potsdam unterentwickelt / ViP lässt sich von EEG-Umlage befreien

Kraniche und Wildgänse sind irritiert: Sie finden es zu warm, um abzureisen, und vergessen, sich ihre Fettpolster anzufressen. Die Tiere ziehen sogar tagsüber ihre Bahnen am Himmel – ein Glück für Vogelkundler.
Berlin - Nach der mehrfach verschobenen Eröffnung des Großflughafens BER wächst der Druck auf Flughafen-Chef Rainer Schwarz. Der Chef der Sonderkommission im Bundesverkehrsministerium, Michael Odenwald, erhob am Wochenende schwere Vorwürfe.
öffnet in neuem Tab oder Fenster